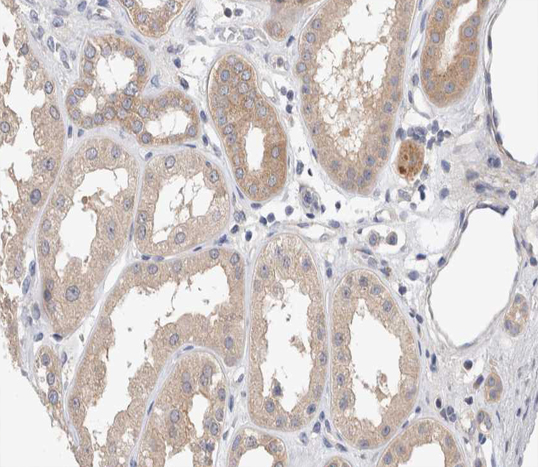
product-image-AAA321473_IHC13.jpg

Rabbit Amyloid beta A4 Polyclonal Antibody | anti-APP antibody
Phospho-Amyloid beta A4 (Thr743/668) Antibody
Phosphate buffered saline, pH 7.4, 150mM NaCl, 0.02% sodium azide and 50% glycerol.
WB (Western Blot)
(Western blot analysis of Amyloid beta A4 phosphorylation expression in HeLa whole cell lysates, The lane on the left is treated with the antigen-specific peptide.)
IF (Immunofluorescence)
(AAA321473 staining HeLa by IF/ICC. The sample were fixed with PFA and permeabilized in 0.1% Triton X-100, then blocked in 10% serum for 45 minutes at 25 degree C. The primary antibody was diluted at 1/200 and incubated with the sample for 1 hour at 37 degree C. An Alexa Fluor 594 conjugated goat anti-rabbit IgG (H+L) Ab, diluted at 1/600, was used as the secondary antibody.)
WB (Western Blot)
(Western blot analysis of Phospho-Amyloid beta A4 (Thr743/668) expression in various lysates)
IHC (Immunohiostchemistry)
(AAA321473 at 1/200 staining human kidney tissue sections by IHC-P. The tissue was formaldehyde fixed and a heat mediated antigen retrieval step in citrate buffer was performed. The tissue was then blocked and incubated with the antibody for 1.5 hours at 22 degree C. An HRP conjugated goat anti-rabbit antibody was used as the secondary.)
IF (Immunofluorescence)
(AAA321473 staining Hela cells by ICC/IF. Cells were fixed with PFA and permeabilized in 0.1% saponin prior to blocking in 10% serum for 45 minutes at 37 degree C. The primary antibody was diluted 1/400 and incubated with the sample for 1 hour at 37 degree C. A Alexa Fluor 594 conjugated goat polyclonal to rabbit IgG (H+L), diluted 1/600 was used as secondary antibody.)
Function: Functions as a cell surface receptor and performs physiological functions on the surface of neurons relevant to neurite growth, neuronal adhesion and axonogenesis. Involved in cell mobility and transcription regulation through protein-protein interactions. Can promote transcription activation through binding to APBB1-KAT5 and inhibits Notch signaling through interaction with Numb. Couples to apoptosis-inducing pathways such as those mediated by G(O) and JIP. Inhibits G(o) alpha ATPase activity (By similarity). Acts as a kinesin I membrane receptor, mediating the axonal transport of beta-secretase and presenilin 1. Involved in copper homeostasis/oxidative stress through copper ion reduction. In vitro, copper-metallated APP induces neuronal death directly or is potentiated through Cu2+-mediated low-density lipoprotein oxidation. Can regulate neurite outgrowth through binding to components of the extracellular matrix such as heparin and collagen I and IV. The splice isoforms that contain the BPTI domain possess protease inhibitor activity. Induces a AGER-dependent pathway that involves activation of p38 MAPK, resulting in internalization of amyloid-beta peptide and leading to mitochondrial dysfunction in cultured cortical neurons. Provides Cu2+ ions for GPC1 which are required for release of nitric oxide (NO) and subsequent degradation of the heparan sulfate chains on GPC1.
Subunit Structure: Binds, via its C-terminus, to the PID domain of several cytoplasmic proteins, including APBB family members, the APBA family, MAPK8IP1, SHC1 and, NUMB and DAB1 (By similarity). Binding to DAB1 inhibits its serine phosphorylation (By similarity). Interacts (via NPXY motif) with DAB2 (via PID domain); the interaction is impaired by tyrosine phosphorylation of the NPXY motif. Also interacts with GPCR-like protein BPP, FPRL1, APPBP1, IB1, KNS2 (via its TPR domains) (By similarity), APPBP2 (via BaSS) and DDB1. In vitro, it binds MAPT via the MT-binding domains (By similarity). Associates with microtubules in the presence of ATP and in a kinesin-dependent manner (By similarity). Interacts, through a C-terminal domain, with GNAO1. Amyloid-beta protein 42 binds CHRNA7 in hippocampal neurons. Amyloid-beta associates with HADH2. Soluble APP binds, via its N-terminal head, to FBLN1. Interacts with CPEB1 and AGER (By similarity). Interacts with ANKS1B and TNFRSF21. Interacts with ITM2B. Interacts with ITM2C. Interacts with IDE. Can form homodimers; this is promoted by heparin binding. Amyloid-beta protein 40 interacts with S100A9. CTF-alpha product of APP interacts with GSAP. Interacts with SORL1. Interacts with PLD3. Interacts with VDAC1 (PubMed:25168729). Interacts with NSG1; could regulate APP processing (By similarity).
Post-translational Modifications: Proteolytically processed under normal cellular conditions. Cleavage either by alpha-secretase, beta-secretase or theta-secretase leads to generation and extracellular release of soluble APP peptides, S-APP-alpha and S-APP-beta, and the retention of corresponding membrane-anchored C-terminal fragments, C80, C83 and C99. Subsequent processing of C80 and C83 by gamma-secretase yields P3 peptides. This is the major secretory pathway and is non-amyloidogenic. Alternatively, presenilin/nicastrin-mediated gamma-secretase processing of C99 releases the amyloid-beta proteins, amyloid-beta protein 40 and amyloid-beta protein 42, major components of amyloid plaques, and the cytotoxic C-terminal fragments, gamma-CTF(50), gamma-CTF(57) and gamma-CTF(59). Many other minor amyloid-beta peptides, amyloid-beta 1-X peptides, are found in cerebral spinal fluid (CSF) including the amyloid-beta X-15 peptides, produced from the cleavage by alpha-secretase and all terminating at Gln-686. Proteolytically cleaved by caspases during neuronal apoptosis. Cleavage at Asp-739 by either caspase-6, -8 or-9 results in the production of the neurotoxic C31 peptide and the increased production of amyloid-beta peptides. N-and O-glycosylated. O-glycosylation on Ser and Thr residues with core 1 or possibly core 8 glycans. Partial tyrosine glycosylation (Tyr-681) is found on some minor, short amyloid-beta peptides (amyloid-beta 1-15, 1-16, 1-17, 1-18, 1-19 and 1-20) but not found on amyloid-beta protein 38, amyloid-beta protein 40 nor on amyloid-beta protein 42. Modification on a tyrosine is unusual and is more prevelant in AD patients. Glycans had Neu5AcHex(Neu5Ac)HexNAc-O-Tyr, Neu5AcNeu5AcHex(Neu5Ac)HexNAc-O-Tyr and O-AcNeu5AcNeu5AcHex(Neu5Ac)HexNAc-O-Tyr structures, where O-Ac is O-acetylation of Neu5Ac. Neu5AcNeu5Ac is most likely Neu5Ac 2, 8Neu5Ac linked. O-glycosylations in the vicinity of the cleavage sites may influence the proteolytic processing. Appicans are L-APP isoforms with O-linked chondroitin sulfate. Phosphorylation in the C-terminal on tyrosine, threonine and serine residues is neuron-specific. Phosphorylation can affect APP processing, neuronal differentiation and interaction with other proteins. Phosphorylated on Thr-743 in neuronal cells by Cdc5 kinase and Mapk10, in dividing cells by Cdc2 kinase in a cell-cycle dependent manner with maximal levels at the G2/M phase and, in vitro, by GSK-3-beta. The Thr-743 phosphorylated form causes a conformational change which reduces binding of Fe65 family members. Phosphorylation on Tyr-757 is required for SHC binding. Phosphorylated in the extracellular domain by casein kinases on both soluble and membrane-bound APP. This phosphorylation is inhibited by heparin. Extracellular binding and reduction of copper, results in a corresponding oxidation of Cys-144 and Cys-158, and the formation of a disulfide bond. In vitro, the APP-Cu+ complex in the presence of hydrogen peroxide results in an increased production of amyloid-beta-containing peptides.Trophic-factor deprivation triggers the cleavage of surface APP by beta-secretase to release sAPP-beta which is further cleaved to release an N-terminal fragment of APP (N-APP).Amyloid-beta peptides are degraded by IDE.
Similarity: The basolateral sorting signal (BaSS) is required for sorting of membrane proteins to the basolateral surface of epithelial cells.The NPXY sequence motif found in many tyrosine-phosphorylated proteins is required for the specific binding of the PID domain. However, additional amino acids either N-or C-terminal to the NPXY motif are often required for complete interaction. The PID domain-containing proteins which bind APP require the YENPTY motif for full interaction. These interactions are independent of phosphorylation on the terminal tyrosine residue. The NPXY site is also involved in clathrin-mediated endocytosis. Belongs to the APP family.
NCBI and Uniprot Product Information
Predicted: 87 kDa
Customer Reviews
Loading reviews...
Share Your Experience
Similar Products
Product Notes
The APP app (Catalog #AAA321473) is an Antibody produced from Rabbit and is intended for research purposes only. The product is available for immediate purchase. The Phospho-Amyloid beta A4 (Thr743/668) Antibody reacts with Human, Mouse, Rat and may cross-react with other species as described in the data sheet. AAA Biotech's Amyloid beta A4 can be used in a range of immunoassay formats including, but not limited to, ELISA, ICC (Immunocytochemistry), IF (Immunofluorescence), IHC (Immunohistochemistry), WB (Western Blot). Researchers should empirically determine the suitability of the APP app for an application not listed in the data sheet. Researchers commonly develop new applications and it is an integral, important part of the investigative research process. It is sometimes possible for the material contained within the vial of "Amyloid beta A4, Polyclonal Antibody" to become dispersed throughout the inside of the vial, particularly around the seal of said vial, during shipment and storage. We always suggest centrifuging these vials to consolidate all of the liquid away from the lid and to the bottom of the vial prior to opening. Please be advised that certain products may require dry ice for shipping and that, if this is the case, an additional dry ice fee may also be required.Precautions
All products in the AAA Biotech catalog are strictly for research-use only, and are absolutely not suitable for use in any sort of medical, therapeutic, prophylactic, in-vivo, or diagnostic capacity. By purchasing a product from AAA Biotech, you are explicitly certifying that said products will be properly tested and used in line with industry standard. AAA Biotech and its authorized distribution partners reserve the right to refuse to fulfill any order if we have any indication that a purchaser may be intending to use a product outside of our accepted criteria.Disclaimer
Though we do strive to guarantee the information represented in this datasheet, AAA Biotech cannot be held responsible for any oversights or imprecisions. AAA Biotech reserves the right to adjust any aspect of this datasheet at any time and without notice. It is the responsibility of the customer to inform AAA Biotech of any product performance issues observed or experienced within 30 days of receipt of said product. To see additional details on this or any of our other policies, please see our Terms & Conditions page.Item has been added to Shopping Cart
If you are ready to order, navigate to Shopping Cart and get ready to checkout.